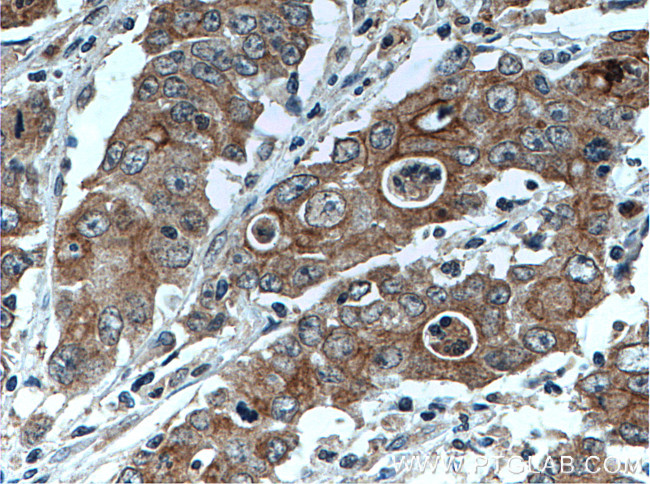
ATG4A Antibody in Immunohistochemistry (Paraffin) (IHC (P))

Search
Proteintech
ATG4A Polyclonal Antibody
{{$productOrderCtrl.translations['antibody.pdp.commerceCard.promotion.promotions']}}
{{$productOrderCtrl.translations['antibody.pdp.commerceCard.promotion.viewpromo']}}
{{$productOrderCtrl.translations['antibody.pdp.commerceCard.promotion.promocode']}}: {{promo.promoCode}} {{promo.promoTitle}} {{promo.promoDescription}}. {{$productOrderCtrl.translations['antibody.pdp.commerceCard.promotion.learnmore']}}
产品信息
27467-1-AP
种属反应
宿主/亚型
分类
类型
抗原
偶联物
形式
浓度
规格
纯化类型
保存液
内含物
保存条件
运输条件
产品详细信息
Immunogen sequence: DEWNSLAVY VSMDNTVVIE DIKKMCRVLP LSADTAGDRP PDSLTASNQS KGTSAYCSAW KPLLLIVPLR LGINQINPVY VDAFKEC (162-247 aa encoded by BC061696 )
靶标信息
Autophagy is the process by which endogenous proteins and damaged organelles are destroyed intracellularly. Autophagy is postulated to be essential for cell homeostasis and cell remodeling during differentiation, metamorphosis, non-apoptotic cell death, and aging. Reduced levels of autophagy have been described in some malignant tumors, and a role for autophagy in controlling the unregulated cell growth linked to cancer has been proposed. This gene encodes a member of the autophagin protein family. The encoded protein is also designated as a member of the C-54 family of cysteine proteases. Transcript variants that encode distinct isoforms have been identified.
仅用于科研。不用于诊断过程。未经明确授权不得转售。
生物信息学
蛋白别名: APG4 autophagy 4 homolog A; ATG4 autophagy related 4 homolog A; AUT-like 2 cysteine endopeptidase; AUT-like 2, cysteine endopeptidase; autophagin 2; Autophagin-2; Autophagy-related cysteine endopeptidase 2; Autophagy-related protein 4 homolog A; Cysteine protease ATG4A; hAPG4A; HsAPG4A; MGC107179; unnamed protein product
基因别名: APG4A; ATG4A; AUTL2; HsAPG4A
UniProt ID: (Human) Q8WYN0
Entrez Gene ID: (Human) 115201